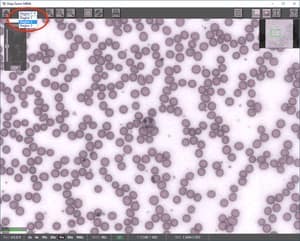
Deep Zoom Viewer-Region Selector

Support
 Viewing Multi-Region Scans
Viewing Multi-Region Scans
Image Viewer
Information in this article applies to:
- uScope Navigator V4.5 and Later
Article ID: NVW1177 — Created: 21 Aug 2019 — Reviewed: 6 Sep 2019
Summary
uScope Navigator v4.5 introduces a region selector to the Deep Zoom Image Viewer when scanning multiple regions of interest from a slide.
uScope Navigator v4.5 introduces a region selector to the Deep Zoom Image Viewer when scanning multiple regions of interest from a slide.
Details
Previous versions of uScope Navigator created multiple regions as separate scans and deep zoom images. uScope Navigator v4.5 now groups multiple scanned regions from the same slide in the same job folder.
In addition, the Deep Zoom image viewer has been updated to provide a drop-down selection box to select the region to display. When you select a different region from the drop-down box, the selected region is immediately loaded and displayed.
 When the region is changed, the scan information dialog is updated to show details for the selected region of interest. The overview image is updated to show the boundary of the selected region.
When the region is changed, the scan information dialog is updated to show details for the selected region of interest. The overview image is updated to show the boundary of the selected region.
Related Articles
- Image Export Sometimes Fails
Image Viewer - Deep Zoom Image Viewer Changes for v4.7
Image Viewer - Multi-Layer Scan Issues
Deep Zoom Images